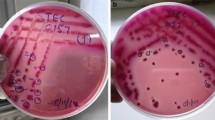

Abstract
Escherichia coli is a faecal indicator and certain virotypes are known as pathogens. Therefore, detection and prevention of E. coli in food is very important. The existing rapid methods concentrate on detecting the pathogenic E. coli instead of total E. coli population. Present study evaluates the use of two molecular markers (uidA and flanking region of uspA) specific for the E. coli in combination with microbiological method for confirmation. Majority of the isolates (77%) were positive for both the genes tested. However, 22% of the E. coli isolates were positive for any one of the two primer sets [uidA (9%) and flanking region of uspA (13%)]. High levels of E. coli incidences (92% samples) were observed in beef while low occurrence (19% samples) was found in sprouts. Low percentage (7.3%) of E. coli isolates was positive for virulence genes tested (lt, ipaH, aggR, eaeA, stx1 and stx2). Two isolates were positive for stx genes. However, none of the isolates including stx positive isolates were E. coli 0157:H7. Maximum number of the E. coli (44%) isolates was characterized under phylogenetic group B2. This phylogenetic group comprises of extra intestinal and virulent E. coli strains.
Similar content being viewed by others
Introduction
Escherichia coli is a commensal organism. Many of the E. coli strains are versatile pathogens (Kaper et al. 2004). Enterohaemorrhagic E. coli (EHEC) strains cause morbidity. Therefore, many epidemiological and molecular pathogenesis studies are carried on EHEC (Strausbaugh 1997). Every year E. coli O157:H7 causes 75,000 cases of foodborne disease (Perna et al. 2001). The E. coli O157 follows an oral route of infection and about 85% of the E. coli O157 infections are food-borne in origin (Friedman et al. 1999, Mead et al. 1999). Contaminated fruits, vegetables and water have been linked to E. coli O157:H7 outbreaks (Ferens and Hovde 2011).
A few rapid methods are reported for identification of E. coli. Chen and Griffiths (1998) have proposed flanking region of uspA gene for the detection of E. coli. Bej et al. (1991) have shown that uidA gene sequence is unique to E. coli. The uidA and tuf gene was used by Maheux et al. (2009) for the detection of E. coli and Shigella strains. However, none of these methods are extensively tested in the field.
Since E. coli gained prominence as a pathogen, studies were carried out to characterize these isolates with respect to virulence genes. Phylogenetic grouping of food and clinical strains of E. coli would help to understand the distribution of such strains in the environment. Clermont et al. (2000) classified E. coli into 4 phylogenetic groups (A, B1, B2 and D groups) based on the presence and absence of the 3 unique regions on E. coli genome.
Nevertheless, detection and confirmation of the E. coli is a time consuming process. Extensive work has been carried out previously to detect the presence of pathogenic E. coli serovars. However, incidence of all strains of E. coli in food and their characterization is lacking. This study focuses on the detection and confirmation of E. coli in Indian food samples using conventional microbiological method (Anonymous 2014) in combination with molecular method. This study also reports the molecular characterization of these E. coli isolates with respect to the incidence of virulence genes and phylogenetic grouping.
Materials and methods
Sample collection and enrichment
One hundred and seventy food samples comprising of chicken (34), mutton (34), beef (22) sprouts including green gram, moth beans, field beans, chick pea, etc. (26), marine fish (28) and pork (26) were analysed for presence of the E. coli from Mumbai, India. All the samples were collected from the local retailers and received at the laboratory within 2 h of purchase. The samples were kept at 4 °C till the analysis.
All microbiological media and chemicals were obtained from Hi-Media (Mumbai, India). Primers were obtained from Integrated DNA technologies (California, US) and all PCR reagents were obtained from Finzyme (San Diego, US).
All the samples were processed as described in US Food and Drug Administration Bacteriological Analytical Manual (Anonymous 2014) with some modifications. In brief, the samples (25 g) were homogenised in 225 mL brain heart infusion (BHI) broth. After incubation at 35 °C for 3 h in static condition, the homogenate was transferred in a 225 mL of double strength tryptone phosphate broth (TPB) for a further incubation of 20 h at 44 °C. A loop full (10 μL) of homogenate was plated on the selective media, MacConkey agar and L-Eosin Methylene Blue (L-EMB) agar, in duplicate. These plates were incubated for 20 h at 35 °C. Typical colonies or in the absence of typical colonies, two atypical colonies from each plate were re-streaked on MacConkey agar and L-EMB agar.
Molecular confirmation of the presumptive positive E. coli
DNA was extracted by boiling a single colony of the presumptive positive cultures in 100 µL of molecular grade water for 5 min, followed by centrifugation (10,000g for 5 min) and 1 µL of the supernatant was used as template DNA for PCR. The confirmation of E. coli was carried out by two PCR reactions. The flanking region of uspA (the universal stress protein) amplification (Table S1) was carried out as described by Chen and Griffiths (1998) and uidA (β-glucuronidase) gene amplification (Table S1) was performed as described by Heijnen and Medema (2006). A multiplex PCR was carried out using uidA and flanking region of uspA primers by the following program; 94 °C for 5 min, 35 cycles of annealing at 55.2 °C for 10 s, extension at 72 °C for 1 min, denaturation at 94 °C for 10 s; and a final extension of 72 °C for 10 min in the thermal cycler (Eppendorf, Germany).The amplified DNA (5 μL per lane) was run on a 2% agarose gel at constant 70 V. The gel was visualized under UV light.
Biochemical and serology tests
Biochemical tests were carried out for the untypable E. coli strains. Also the isolates that were positive for amplification by one set of primers were confirmed as the E. coli by the above tests using the US-FDA (Anonymous 2014). Major biochemical tests done for evaluating E. coli were IMViC (Indole, Methyl red, Vogous prosker and citrate) tests.
Serology with respect to O and H antigen was carried out at National Centre for Salmonella and Escherichia, Central Research Institute, Kasauli, India of the isolates that were positive for the presence of virulence genes (Table 2).
Determination of virulent variants
The isolates were examined for stx1 and stx2, to identify the EHEC (Enterohemorrhagic E. coli) strains; eaeA, intimin for EPEC (Enteropathogenic E. coli) attaching and effacing; aggR for EAEC (Enteroaggregative E. coli); ipaH for EIEC (Enteroinvasive E. coli); lt for heat labile; st for heat stable toxin; for ETEC (Enterotoxigenic E. coli) and daaD for DAEC (Diffusely adherent E. coli) using the primers specific to the above genes as described by Guion et al. (2008). The presence of stx1 and stx2 genes was further confirmed using the probe based real time PCR as described by US-FDA (Anonymous 2014). All the E. coli isolates were screened for the presence of +93 uidA gene (Anonymous 2014) specific for the O157:H7 serotype by real time PCR (Anonymous 2014) and also plated on MUG (4-methylumbelliferyl β-d-glucuronide) sorbitol agar according to the US-FDA (Anonymous 2014).
E. coli phylogenetic grouping
The E. coli phylogenetic grouping was determined by the amplification of DNA targets using a single multiplex PCR as described by Clermont et al. (2000). The genomic DNA isolated from each E. coli strain was used for amplification of the chuA, yjaA and DNA fragment TSPE4.C2. The amplified DNA (5 μL per lane) was run on a 2% agarose gel at constant 70 V. The gel was visualized under UV light. Based on the presence or absence of 3 DNA markers (chuA, yjaA and DNA fragment TSPE4.C2) isolates were assigned to specific phylogenetic groups as per the scheme proposed by Clermont et al. (2000).
Results and discussion
uidA and uspA as marker genes for the confirmation of E. coli from food samples
A total of 448 presumptive positive isolates of E. coli were isolated from food samples by biochemical method. Typical colonies from the selective plates were confirmed by two E. coli specific primers for the marker gene (uspA and uidA). Isolates which were positive for both the sets of primers and either of the two primers were considered as E. coli. 149 isolates (79%) from the food samples tested were positive for the presence of the marker genes, uidA and flanking regions of uspA (Fig S2). However, we observed that 43 (22%) of the E. coli isolates were positive for any one of the two primer sets [uidA (9%) and flanking region of uspA (13%)]. The uidA gene has been shown to be very specific to E. coli; however, primers specific to this region also amplifies few species of Shigella (Bej et al. 1991). Heijnen and Medema (2006) have shown that modified primer set for uidA detected not only all E. coli isolates tested, but also 54% of the Shigella species. To address this shortcoming of uidA primers, we included E. coli specific primer set for flanking region of uspA (Chen and Griffiths 1998). Twenty two percent of the E. coli isolates which were positive for either one of the two E. coli specific primers were further confirmed by additional biochemical tests and were found to be positive for E. coli. Eight per cent of atypical colonies on L-EMB and MacConkey plates were positive for E. coli by PCR. Thus, atypical colonies on selective plate should be tested for E. coli. Although, molecular confirmation is better than phenotypic detection, there are possibilities that molecular detection based on one marker gene may give false negative results. Hence, the present study suggests the use of multiple markers for confirmation of E. coli. These two sets of primers can be run as multiplex PCR (Data not shown). In recent work Molina et al. (2015) have shown that yaiO and lacZ3 primers are unique to E. coli. However, these primers are tested with limited number of samples and not tested in field. PCR based confirmation of typical and atypical colonies obtained on selective plate for E. coli would increase speed and accuracy of the identification (Fig S1).
Prevalence of E. coli in Indian food samples
E. coli is a faecal coliform used as an indicator of human enteric pathogens (Orskov et al. 1987). Therefore, the occurrence of E. coli in high percentage of food samples indicates poor hygiene of the food samples. More than half of the food samples tested was positive for E. coli (Table 1). High level (91%) incidence of E. coli was observed in beef samples and a comparatively low occurrence in the sprouts (19%) (Table 1). There are many reports of incidence of E. coli in food from different parts of the world. In a study from Mexico street food, 44% of the samples were positive for E. coli (Estrada-Garci et al. 2004). Li et al. (2004) have shown that 38% of bison carcasses are contaminated with E. coli. There is a possibility of non-pathogenic E. coli may acquire virulence genes by horizontal gene transfer and results in emergence of virulent strains (Ochman et al. 2000).
Incidence of virulence genes in the E. coli
All 192 isolates were characterized with respect to virulence genes and occurrence of the O157:H7 serotype using rapid and multiplex PCR method (Guion et al. 2008). In the current study, 7.3% of the E. coli isolates were positive for virulence genes (Table 1). All the E. coli isolates from sprout samples were negative for virulence genes tested. The E. coli isolated from mutton showed high incidence of virulence genes (21%) (Table 2). Previous report has shown the incidence of pathogenic E. coli in beef, chicken, pork and other animal meats (Magwedere et al. 2013). Isolates which showed presence of virulence genes were serotyped; 4 isolates belonged to O124, contained lt, aggR and eaeA genes, 2 isolates which showed presence of stx genes were categorized as E. coli rough strain and rest of the isolates were characterized as untypable E. coli (UT E. coli) (Table 2); however, isolates characterized as UT E. coli were positive for both the E. coli marker genes (flanking region of uspA and uidA) and positive for IMViC tests. E. coli O157:H7 was absent in all the food samples tested. Few studies have reported the incidence of E. coli O157:H7 in food samples from India (Verma et al. 2013). In an epidemiological survey of 17,000 E. coli isolates from food and clinical samples, low incidence of E. coli O157 was observed (Sehgal et al. 2008). Bindu and Krishnaiah (2010) have shown the presence of virulence genes in E. coli with special reference to stx1 and stx2. In the current study, toxin genes stx1 and stx2 were found in one E. coli isolate from the mutton sample and the presence of stx1 was detected in one isolate from the beef sample. The incidence of both stx1 and stx2 gene was not observed in any of the E. coli isolate.
Similar to our results, Sheikh et al. (2013) observed low incidence of stx genes in E. coli isolates of India.
Distribution of phylogenetic groups in E. coli
In this study, 192 E. coli isolates obtained from different food samples were assigned to four phylogenetic groups (A, B1, B2 and D). Maximum number of the E. coli isolates (44%) were characterized under group B2. This is a significant observation because majority of the extra intestinal and virulent E. coli were classified under phylogenetic group B2 (Bingen et al. 1998). This result is consistent with the previous study by Rugeles et al. (2010). The group B2 is the most prevalent phylogenetic group in meat samples. Three percent of the isolates belonged to group D which also represents the virulent E. coli (Bingen et al. 1998). Thus, 47% of the isolates obtained from these food samples belong to two phylogenetic groups of E. coli which represent pathogenic E. coli. In this study, the phylogenetic groups A and B1 constituted of 16% and 29%, respectively. Group B2 commonly occurred among pork (53%), beef (72%), mutton (47%) and fish (33%). Chicken (18%) and sprouts (25%) mainly showed the presence of D group. Virulence gene positive E. coli isolates (7.3%) belonged to the B1, B2 and A group. Group B2 was the major phylogenetic group in all food samples of animal origin. This observation suggests that major reservoir of pathogenic E. coli are animals.
Conclusion
The combination of molecular and biochemical confirmation of E. coli is rapid and specific as compared to conventional identification method. The pair of DNA marker (uspA and uidA) is more accurate for the confirmation of E. coli than any one single DNA marker. In this study, beef samples showed the high incidence of E. coli. High percentages of food samples were positive for E. coli. 7% of E. coli isolates were positive for virulence genes tested. Two E. coli isolates were positive for stx genes. However, all the samples tested were free of E. coli O157:H7. More than one-third of isolates were categorized under phylogenetic group B2 which is known to contain extra intestinal and virulent E. coli strains.
References
Anonymous (2014) United States food and drug administration (USFDA). Online bacteriological analytical manual revised edition, 8th ed, Arlington: US food and drug administration. http://www.fda.gov/Food/FoodScienceResearch/LaboratoryMethods/ucm070080.html. Accessed on 9 Dec 2014
Bej AK, Dicesare JL, Haff L, Atlas RM (1991) Detection of Escherichia coli and Shigella spp. in water by using the polymerase chain reaction and gene probes for uid. Appl Environ Microbiol 57:1013–1017
Bindu CK, Krishnaiah N (2010) Detection of Escherichia coli O157:H7 prevalence in foods of animal origin by cultural methods and PCR technique. Vet World 3(1):13–16
Bingen E, Picard B, Brahimi N, Mathy S, Desjardins P, Elion J, Denamur E (1998) Phylogenetic analysis of Escherichia coli strains causing neonatal meningitis suggests horizontal gene transfer from a predominant pool of highly virulence B2 group strains. J Infect Dis 177:642–650
Chen J, Griffiths MW (1998) PCR differentiation of Escherichia coli from other gram-negative bacteria using primers derived from the nucleotide sequences flanking the gene encoding the universal stress protein. Lett Appl Microbiol 27:369–371
Clermont O, Bonacorsi S, Bingen E (2000) Rapid and simple determination of the Escherichia coli phylogenetic group. Appl Environ Microbiol 66:4555–4558
Estrada-Garci T, Lopez-Saucedo C, Zamarripa-Ayala B, Thompson MR, Gutierrez-Cogco L, Mancera-Martinez A, Escobar-Gutierrez A (2004) Prevalence of Escherichia coli and Salmonella spp. in street-vended food of open markets (tianguis) and general hygienic and trading practices in Mexico city. Epidemiol Infect 132:1181–1184
Ferens WA, Hovde CJ (2011) Escherichia coli O157:H7: animal reservoir and sources of human infection. Foodborne Pathog Dis 8:465–487
Friedman MS, Roels T, Koehler JE, Feldman L, Bibb WF, Blake P (1999) Escherichia coli O157:H7 outbreak associated with an improperly chlorinated swimming pool. Clin Infect Dis 29:298–303
Guion CE, Ochoa TJ, Walker CM, Barletta F, Cleary TG (2008) Detection of diarrheagenic Escherichia coli by use of melting-curve analysis and real-time multiplex PCR. J Clin Microbiol 46:1752–1757
Heijnen L, Medema G (2006) Quantitative detection of E. coli, E. coli O157 and other toxin producing E. coli in water samples using a culture method combined with real-time PCR. J Water Health 4:487–498
Kaper JB, Nataro JP, Mobley HL (2004) Pathogenic Escherichia coli. Nat Rev Microbiol 2:123–140
Li Q, Sherwood JS, Logue CM (2004) The prevalence of Listeria, Salmonella, Escherichia coli and E. coli O157:H7 on bison carcasses during processing. Food Microbiol 21:791–799
Magwedere K, Dang HA, Mills EW, Cutter CN, Roberts EL, Debroy C (2013) Incidence of Shiga toxin-producing Escherichia coli strains in beef, pork, chicken, deer, boar, bison, and rabbit retail meat. J Vet Diagn Invest 25:254–258
Maheux AF, Picard FJ, Boissinot M, Bissonnette L, Paradis S, Bergeron MG (2009) Analytical comparison of nine PCR primer sets designed to detect the presence of Escherichia coli/Shigella in water samples. Water Res 43:3019–3028
Mead PS, Slutsker L, Dietz V, Mccaig LF, Bresee JS, Shapiro C, Griffin PM, Tauxe RV (1999) Food-related illness and death in the United States. Emerg Infect Dis 5:607–625
Molina F, López-Acedo E, Tabla R, Roa I, Gómez A, Rebollo JE (2015) Improved detection of Escherichia coli and coliform bacteria by multiplex PCR. BMC Biotechnol 4:15–48
Ochman H, Lawrence JG, Groisman EA (2000) Lateral gene transfer and the nature of bacterial innovation. Nature 405(6784):299–304
Orskov F, Orskov I, Villar JA (1987) Cattle as reservoir of verotoxin-producing Escherichia coli O157:H7. Lancet 2:276
Perna NT, Plunkett G, Burland V, Mau B, Glasner JD, Rose DJ (2001) Genome sequence of enterohaemorrhagic Escherichia coli O157:H7. Nature 409:529–533
Rugeles LC, Bai J, Martinez AJ, Vanegas MC, Gomez-Duarte OG (2010) Molecular characterization of diarrheagenic Escherichia coli strains from stools samples and food products in Colombia. Int J Food Microbiol 138:282–286
Sehgal R, Kumar Y, Kumar S (2008) Prevalence and geographical distribution of Escherichia coli O157 in India: a 10-year survey. Trans R Soc Trop Med Hyg 102:380–383
Sheikh JA, Rashid M, Rehman MU, Bhat MA (2013) Occurrence of multidrug resistance shiga-toxin producing Escherichia coli from milk and milk products. Vet World 6:915–918
Strausbaugh LJ (1997) Emerging infectious diseases: a challenge to all. Am Fam Physician 55:111–117
Verma S, Kumar M, Kashyap S, Singh M, Venkatesh V (2013) Current senario of Escherichia coli and its serotype ‘‘O157:H7’’ in Indian subcontinent. IJIRSET 2:2641–2644
Author information
Authors and Affiliations
Corresponding author
Ethics declarations
Conflict of interest
There is no conflict of interest to declare.
Electronic supplementary material
Below is the link to the electronic supplementary material.
Rights and permissions
Open Access This article is licensed under a Creative Commons Attribution 4.0 International License, which permits use, sharing, adaptation, distribution and reproduction in any medium or format, as long as you give appropriate credit to the original author(s) and the source, provide a link to the Creative Commons licence, and indicate if changes were made.
The images or other third party material in this article are included in the article’s Creative Commons licence, unless indicated otherwise in a credit line to the material. If material is not included in the article’s Creative Commons licence and your intended use is not permitted by statutory regulation or exceeds the permitted use, you will need to obtain permission directly from the copyright holder.
To view a copy of this licence, visit https://creativecommons.org/licenses/by/4.0/.
About this article
Cite this article
Godambe, L.P., Bandekar, J. & Shashidhar, R. Species specific PCR based detection of Escherichia coli from Indian foods. 3 Biotech 7, 130 (2017). https://doi.org/10.1007/s13205-017-0784-8
Received:
Accepted:
Published:
DOI: https://doi.org/10.1007/s13205-017-0784-8